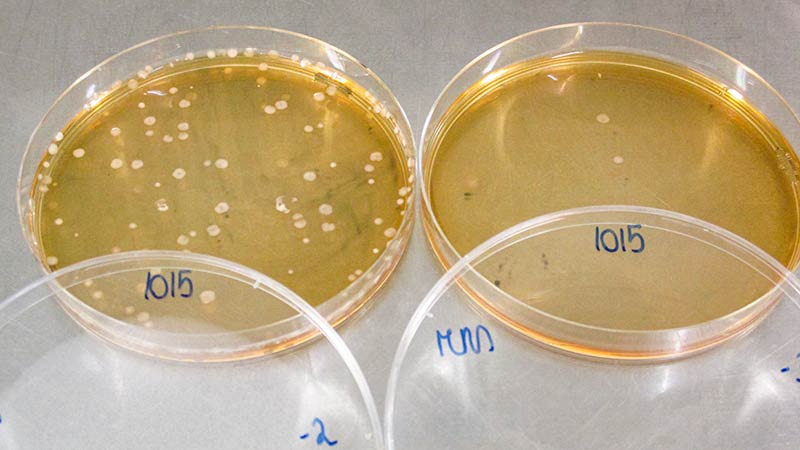

Hoe wij yoghurt testen?
Yoghurt is een product boordevol goede voedingsstoffen. Wij onderwierpen 34 soorten yoghurt aan een test: 19 gewone soorten magere yoghurt, maar ook 15 plantaardige alternatieven op basis van soja, amandel en kokos. Zie hier hoe wij onze verschillende tests uitvoeren en welke yoghurt het label "Beste uit de Test" en "Beste koop" krijgt.
Yoghurt is een bron van goede eiwitten, calcium en vitamine B. In onze laatste tests hebben we 19 "normale" magere yoghurts (maximum 1% vet) en 15 plantaardige alternatieven op basis van soja, amandelen, rijst, kokosnoot, enz. opgenomen, allemaal met een Nutri-Score A of B. Deze producten zijn standyoghurt én roeryoghurt, maar geen gearomatiseerde, Griekse yoghurt, die met toegevoegde room of de drinkbare varianten.
In onze koopwijzer vind je de 19 soorten magere natuuryoghurt en 15 soorten alternatieve plantaardige yoghurt.
We hebben zowel de samenstelling, smaak, geur en etikettering van de yoghurt geanalyseerd. Ook maakten we een prijsvergelijking. Deze analyses vonden plaats in januari en februari 2022. De prijzen werden verzameld in maart 2022.
Hoe kregen sommige yoghurts onze kwaliteitslabels? Waarom zijn sommige yoghurts volgens ons de beste? In dit dossier vertellen wij je meer over:
- De etiketten van de 19 natuuryoghurts en 15 plantaardige alternatieven;
- Hun samenstelling, de daadwerkelijke aanwezigheid van de melkfermenten die essentieel zijn voor de naam "yoghurt", het drogestofgehalte, het vetprofiel, enz...
- En tenslotte, hun smaak.
=> Verplichte info
We onderzochten eerst of het etiket wel degelijk alle verplichte gegevens vermeldde, zoals:
- de vervaldatum;
- het adres van de producent of distributeur;
- de ingrediëntenlijst;
- het nettogewicht;
- de voedingswaarde.
Op dit vlak waren alle producten perfect in orde.
=> Facultatieve informatie
Daarnaast keken we ook naar facultatieve info die volgens ons helpt bij het kiezen van het juiste product in de winkel. Het gaat dan bijvoorbeeld om:
- De oorsprong van de hoofdbestanddelen (vooral van de melk).
- Het land van productie: ook zonder expliciete vermelding is het mogelijk om dit na te gaan aan de hand van het Europese identificatienummer (EU-identificatienummer).
- De Nutri-Score of gelijkwaardig, met vermelding aan de voorzijde van de verpakking.
- Voedingswaardes: het zou handig zijn als de verpakking systematisch de volledige voedingswaarde van de yoghurt zou vermelden. Het gaat daarbij om de aanwezigheid en de precieze hoeveelheid van voedingsstoffen (met name van vezels, die slechts facultatief moeten worden vermeld). Deze aanduiding gebeurt bij voorkeur per portie en per 100 g en in een duidelijke tabelvorm.
- Het aantal porties per verpakking en aanduiding van de grootte van de porties.
- Contactgegevens van de producent (e-mail of telefoonnummer).
- Productiedatum.
- Bewaarinstructies na opening.
- Het type vervaldatum naast de datum zelf.
- Een aanduiding die je aanmoedigt te kijken, ruiken en proeven voordat je het weggooit.
- Aanduiding van het type yoghurt (roer- of standyoghurt).
=> Compositie
Melkzuurbacteriën
Om de benaming "yoghurt" te krijgen, moet deze uit gefermenteerde melk bereide bereiding twee zeer specifieke bacteriën bevatten (ook "melkzuurbacteriën" genoemd): Lactobacillus bulgaricus en Streptococcus thermophilus. Bovendien moeten van beide bacteriën minstens 10 miljoen stuks per gram levend aanwezig zijn op het moment van levering bij de consument.
We voeren verschillende tests uit in het labo.
Als deze bacteriën niet aanwezig zijn in het product of niet meer levend zijn na een thermische behandeling, wordt het product niet meer beschouwd als "yoghurt" maar wel als een melkspecialiteit.
In onze test controleerden we dus in hoeverre deze bacteriën op de vervaldatum nog aanwezig waren. Als beide soorten bacteriën in grote hoeveelheden aanwezig zijn, krijgt het product een goede score voor dit criterium. Indien ook andere bacteriën op het etiket worden vermeld, kwantificeren en evalueren wij deze ook.
Vetzurenprofiel
Bij de plantaardige alternatieven uit onze test werd het vetzuurprofiel beoordeeld. Hoe meer onverzadigde vetzuren, hoe hoger de score.
Drogestofgehalte
We hebben ook het gehalte vetvrije melkdroge stof in onze stalen gemeten. De droge stof is belangrijk omdat deze onder andere proteïnes, suikers, vitamines enz. bevat.
We wilden er zeker van zijn dat onze onderzochte producten voldoende droge stof bevatten (dus het wettelijke minimum van 8,2 %). Hoe hoger de hoeveelheid droge stof, hoe beter de score voor deze parameter. Het verschil is te wijten aan het feit dat er vóór de fermentatie bij sommige yoghurts melkpoeder werd toegevoegd om ze steviger te maken.
Voor de plantaardige alternatieven is er geen wettelijk minimum, maar de droge stofgehalten zijn over het algemeen lager dan voor yoghurt, waardoor wij een minder uitgesproken beoordelingsschaal hanteren.
Bewerkingsgraad
Wij hebben de mate van bewerking van plantaardige alternatieven voor yoghurt beoordeeld, aangezien deze producten kleurstoffen, zuurteregelaars, verdikkingsmiddelen, enz. kunnen bevatten. Wat is een ultraberwerkt product? Ons dossier legt je meer uit:
Bekijk ons dossier ultrabewerkte voeding
Lees meer over voedingsadditieven
Nettogewicht
Wij hebben het nettogewicht van de yoghurt in het laboratorium gecontroleerd, maar wij hebben geen tekorten van meer dan 1% gevonden (wat onder de wettelijke grens ligt).
=> Smaak
Een expertenpanel onderwierp de yoghurts aan een smaaktest en noteerde zijn bevindingen. Elke yoghurt kreeg een score van onze “proevers” op het vlak van smaak en geur. Daarbij werd ook rekening gehouden met andere aspecten, zoals de bitterheid, zoetheid en zuurtegraad.
Bekijk de testresultaten van yoghurt

Onze testers beoordelen verschillende parameters.
